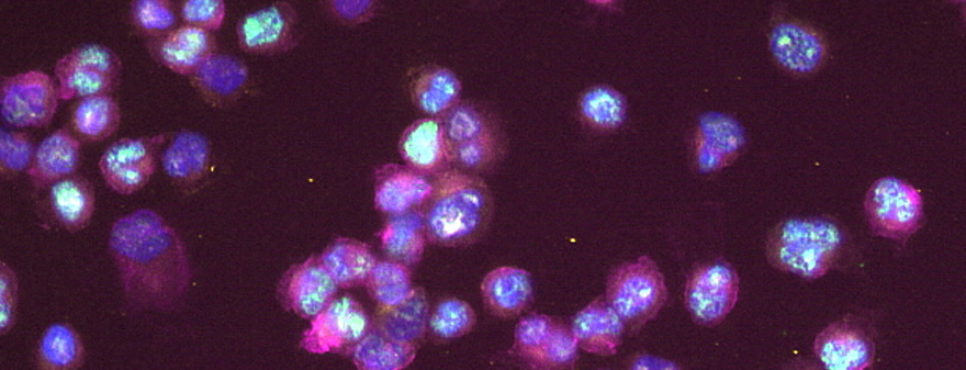

Program Committee
Giada Bianchi, Dana-Farber Cancer Institute, Boston, Massachusetts
Faith E. Davies, New York University Langone Health, New York, New York
Francesca Gay, University of Torino, Torino, Italy
Jonathan J. Keats, TGen (The Translational Genomics Research Institute), Phoenix, Arizona
Salomon Manier, University of Lille, Lille, France
Paola Neri, University of Calgary, Calgary, AB, Canada
Bruno Paiva, University de Navarra, Pamplona, Spain
Nina Shah, University of California San Francisco, San Francisco, California
Eric L. Smith, Memorial Sloan Kettering Cancer Center, New York, New York
Rodger E. Tiedemann, Princess Margaret Cancer Centre, Toronto, ON, Canada
Brian Walker, University of Arkansas for Medical Sciences, Little Rock, Arkansas